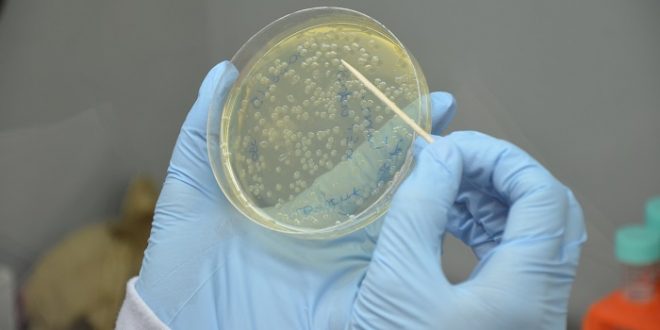

A pesquisa de insumos biológicos em Goiás ganhará o reforço de 13 biofábricas a partir de 2022. O investimento de R$ 8 milhões para o desenvolvimento e a disseminação da tecnologia foi anunciado pela Secretaria de Estado de Agricultura, Pecuária e Abastecimento (Seapa). Goiás pretende ter o maior ecossistema de inovação em bioinsumos do Brasil.
Os equipamentos para as biofábricas começarão a ser adquiridos agora de 2022, com recursos do Tesouro Estadual. Nove biofábricas serão instaladas em unidades do IF Goiano, no interior do Estado; duas na Universidade Estadual de Goiás (UEG), em Anápolis; e mais duas na Universidade Federal de Goiás (UFG), em Goiânia. A UEG prevê ainda o aporte de recursos em uma linha de pesquisa específica sobre bioinsumos.
O titular da Seapa, Tiago Mendonça, destaca as vantagens dos insumos biológicos. “São produtos de baixo impacto ambiental, que reduzem custos e aumentam a qualidade da produção. Produzindo bioinsumos dentro da propriedade (on farm), o produtor reduz riscos e garante um maior controle da sua atividade”, afirma. Para ele, neste momento de grande dificuldade provocada pelo aumento dos preços dos insumos importados, os bioinsumos “surgem como uma luz e já são uma das grandes pautas do agro no mundo todo em relação à segurança alimentar”.
Mendonça ressalta o empenho do governador Ronaldo Caiado para viabilizar a iniciativa. “Goiás foi pioneiro na aprovação de uma Lei Estadual de Bioinsumos e que está servindo de modelo para outros Estados. Com todos trabalhando juntos e estes investimentos a caminho, ganharemos novo impulso na pesquisa e disseminação de conhecimento sobre bioinsumos”.
Presidente da Fundação de Amparo à Pesquisa do Estado de Goiás, Robson Vieira explica que parte das estruturas adquiridas para as biofábricas serão destinadas para pesquisa e inovação, outra parte para avaliação de qualidade do produto e transferência de conhecimento ao produtor. “É necessária a pesquisa e também a transferência de conhecimento de forma cuidadosa, com qualidade, criando metodologia, de forma a propiciar redução de custo e aumento da produção lá na ponta”, argumentou. “Este é um trabalho que vai começar no ano que vem e que vai se desenvolver pelos próximos 10 ou 11 anos”, acrescenta. Canal com Seapa
Canal Bioenergia Referência em Bioenergia e Agronegócio